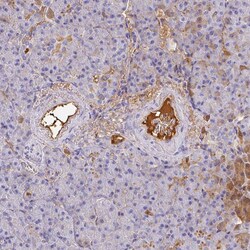
Invitrogen Albumin Polyclonal Antibody 100 &mu;L; Unconjugated:Antibodies

missing translation for 'onlineSavingsMsg'
Learn More
Learn More
Invitrogen™ Albumin Polyclonal Antibody


Rabbit Polyclonal Antibody
Marca: Invitrogen™ PA5111011
Questo articolo non è restituibile.
Consulta la politica di reso
Descrizione
Immunogen sequence: ADLPSLAADF VESKDVCKNY AEAKDVFLGM FLYEYARRHP DYSVVLLLRL AKTYETTLEK CCAAADPHEC YAKVFDEF Highest antigen sequence indentity to the following orthologs: Mouse - 77%, Rat - 79%.
Albumin is a soluble, monomeric protein which comprises about one-half of the blood serum protein. Albumin functions primarily as a carrier protein for steroids, fatty acids, and thyroid hormones and plays a role in stabilizing extracellular fluid volume. Albumin is a globular unglycosylated serum protein of molecular weight 65,000. Albumin is synthesized in the liver as preproalbumin which has an N-terminal peptide that is removed before the nascent protein is released from the rough endoplasmic reticulum. The product, proalbumin, is in turn cleaved in the Golgi vesicles to produce the secreted albumin.
Specifica
| Albumin | |
| Polyclonal | |
| Unconjugated | |
| ALB | |
| ALB; ALB protein; Alb1; Alb-1; albumin; albumin (32 AA); albumin (AA 34); albumin 1; Albza; ANALBA; Bos d 6; bovine serum albumin; BSA; cell growth inhibiting protein 42; FDAH; GIG20; GIG42; growth-inhibiting protein 20; PRO0883; PRO0903; PRO1341; PRO1708; PRO2044; PRO2619; PRO2675; Serum albumin; UNQ696/PRO1341 | |
| Rabbit | |
| Antigen affinity chromatography | |
| RUO | |
| 213 | |
| Store at 4°C short term. For long term storage, store at -20°C, avoiding freeze/thaw cycles. | |
| Liquid |
| Immunohistochemistry (Paraffin), Western Blot, Immunocytochemistry | |
| 0.10 mg/mL | |
| PBS with 40% glycerol and 0.02% sodium azide; pH 7.2 | |
| P02768 | |
| ALB | |
| Recombinant Protein corresonding to Human Human Serum Albumin. Recombinant protein control fragment (Product #RP-102586). | |
| 100 μL | |
| Primary | |
| Human | |
| Antibody | |
| IgG |
Correzione del contenuto del prodotto
Fornite il vostro feedback sul contenuto del prodotto compilando il modulo sottostante.
Titolo del prodotto
Individuate un'opportunità di miglioramento?Condividi una correzione di contenuto